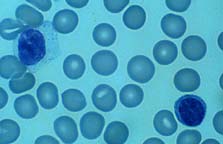
E. Lymphocytes 
 
Link to ... 
Blood Cells and the CBC
Ed Uthman, MD 
Diplomate, American Board of Pathology

|
To understand the chemistry of water we need to know about
pH.
[ The pH notation is an index of Hydrogen's chemical activity in a solution.
pH is a
Log Scale Unit of Measure, and is used to express the degree of acidity of a substance. ]
Very pure water doesn't conduct electricity, but as soon as any substance that ionizes in water is added, you have a conductor owing to the fact that the ionized atoms in the water solution carry the current.
Knowledge of this property gives one a valuable tool for controlling chemical reactions. For one thing, ionized atoms experience acceleration when an electric field is set up within the solution. Ionized Atoms move toward the charge of opposite sign. This effect is used in electroplating to provide a smooth even coating of atoms on your target material. The electric force causes the atoms to move out of the solution at concentration levels far below those of a saturated solution.
Reversing the charge/current will cause the atoms to go back into solution from your material. Electricity can be used to bring materials into solution or to take them out again.
Electroplating can be done without the use of an external power source and wires. "Electro-less Solutions" are available that have their internal electrical forces balanced in such a manner, that when a suitable object is placed in the solution, the metal ions will come out of solution and coat the object.
Again, if the object were to be connected to a proper external power source, the "plated atoms" will come off the object again. And again, if the object were to be placed in an ionic solution with the right properties, the "plated atoms" would also come off again.
This is an important lesson, because all the laws of physics that rule the mineral kingdom are also at work in some way in our bodies. The inside of our body's "pipes" can become coated, even totally plugged, when materials come out of solution. This Process is REVERSABLE !
Dr. T. C. McDaniel has reported success with about 39 diseases working with 10,000 patients. His method is to administer an I.V. solution with the correct electrical properties to adjust blood plasma electrolytes to bring into solution the problem material. This method is based on the applied craft of
Colloidal Science, known and widely used in many branches of chemistry. Dr. McDaniel's method involves mixing salts that are normally found in human blood, (indeed required by the human body) in a crafted manner, so as to achieve the correct electrical potential in our blood's plasma.
|
"Cleaning Up" with "Electric Water"
So, water is the most universal solvent we know about, and we have a flower vase to clean up. Lots of hard mineral stuff on its sides. So we get some "pure water" and scrub and scrub. We can see that it is working, but it is taking too long and using too much "pure water". So, what is the first thing we think of doing ? ...
We Add SOAP !!!
What does the soap do? – It makes the water wetter. – How can wet water get wetter?
We add something to the water that changes the electrical properties of the solution, which then makes it easier for the water molecules to wiggle their way between the unwanted "dirt particles".
Adding a surfactant (a surface-active agent) such as detergent can decrease surface tension, but this will not increase water's carrying capacity unless it changes the basic colloidal chemistry of the liquid by adding a material with negative ions, thereby increasing the Zeta Potenial energy.
 Soap works by breaking up the electric field which creates surface tension. This allows water to "surround its victim and carry it away".
Soap works by breaking up the electric field which creates surface tension. This allows water to "surround its victim and carry it away".
This works fine if your dirt isn't stuck to securely to your surface.
But what if it is "well bonded" and sticks to itself really well, like the minerals on the sides of your vase?
Water's weak electric charge will get the job done if you have enough "pure water" and enough time. But what if you can't use soap, or you want to use less water and less time? You then bring in the ...
Anions( – ) and Cations( + )
! ! ! ! ! ! ! ! ! ! ! ! ! ! ! ! ! ! ! ! ! ! ! ! ! ! ! ! ! ! ! ! ! ! ! ! ! !
Here is a case where the classic notation inhibits the understanding of the subject.
The reason atoms form chemical bonds has more to do with mechanics than it does with electricity. Hydrogen's positive notation when classed as a Cation, is not because it has two positrons and only one electron — hydrogen has only one positron in its nucleus — it is because with only one electron in orbit, it wobbles all over the place and atoms have a strong desire not to —
Inertia you know.
The nature of hydrogen's electron orbit makes it a perfect candidate to receive an additional electron (if the spin is correct) to achieve dynamic balance for the hydrogen's atomic system. Because it can receive an electron it is considered to be a positive entity and is called a Cation. (Electropositive)
On the other side of the binary is the Anion. Chlorine is classed as an Anion. Chlorine has an electron in a somewhat unstable orbit that it would love to share. Since it is providing the electron, it is classed as an Anion.
(Electronegitive)
When Hydrogen and Chlorine get together, they share the electron in a figure 8 orbital that allows them to achieve a symbiotic dynamic stability.
Hydrochloric acid ( H+Cl– ), is what our bodies produce to electrify our stomach fluids. But pure HCl can't do the job by itself.
In order to achieve good dynamic stability, the hydrogen atom and chlorine atom cuddle up real close. It takes water to intervene in this relationship, to allow the electric force to manifest and do its work. The water molecules cuddle up to the hydrogen and chlorine atoms, like so many children wanting to get in on their parent's hugs.
WOW !
So, what about the Flower Vase !
Adding a little HCl (or vinegar) to the pure water in your vase will activate the water's electrical potential giving the solution the power to unlock the atomic bonds that are holding the minerals to the side of your vase.
Result —— A Clean Flower Vase !!!
— Factoid —
Water is diamagnetic (Repelled from a
magnetic field, but not magnetized, more so when cold around 39° F.). This results from the fact that there are two diamagnetic hydrogen atoms and one paramagnetic oxygen atom comprising the water molecule. ...
|
Remember, All this is to convince you to DRINK more Water.
??? How Much Water Should One Drink ???
Dr. Judith Reichman, during a network morning show, perhaps said it best.
We are all individuals, and so are our needs. At times our bodies use large amounts of water to keep us cool. So, the issue resides in not how much water you drink, but in drinking enough water for your body to wash out all the toxins that have acuminated in our blood.
So the bottom line, she says, "is that you drink enough water so that you can Urinate Two Quarts a Day".
Drink Enough Water for your body to keep cool and still have enough to wash out your system.
Vitamin C
{ Vitamin C - Ascorbic Acid; C6H8O6 }
Humans, Apes and Guinea Pigs are the only known mammals who don't have a system for making
Vitamin C in their bodies.
 The presence of the four hydroxyl groups ( OH– ) makes this molecule a very good
Anionic Surfactant.
The presence of the four hydroxyl groups ( OH– ) makes this molecule a very good
Anionic Surfactant.
Thus, Vitamin C has a powerful effect on our blood's
Zeta Potential, keeping our blood cells separated and flowing smoothly.
A ten pound rabbit makes about one–half gram of Vitamin C each day.
( That is 1 gram per 20 pounds of body weight. 1,000 mg. / day / 20 lbs. b.w. )
To match this, a 200–pound man would need to take 10 grams ( 10,000 mg. ) of Vitamin C each day !
A study was done to find out how much Vitamin C was necessary to "saturate" our blood's Lymphocytes
( Provide them with as much as they need )
. The study concluded that it took "4.5 grams per day ( 4,500 mg. ) for a woman and More for men".

E. Lymphocytes
In the immune / inflammatory response, if the neutrophils and monocytes are the brutes, the lymphocytes are the brains. It is possible to observe the horror of life without lymphocyte function by studying the unfortunate few with hereditary, X–linked, severe combined immune deficiency. Such individuals uniformly die of systemic infections at an early age (except for the "bubble boys" of yesteryear, who lived out their short lives in antiseptic prisons). The functions of lymphocytes are so diverse and complex that they are beyond the scope of this text (and the scope of the author, it must be admitted). What follows are a few general remarks concerning examination of lymphocytes in peripheral blood.
After neutrophils, lymphocytes are the most numerous of the circulating leukocytes. The normal range of the lymphocyte count is 1,000 – 4,800/µL. Their life span may vary from several days to a lifetime (as for memory lymphocytes). Unlike neutrophils, monocytes, and eosinophils, the lymphocytes 1.) can move back and forth between the vessels and the extravascular tissues, 2.) are capable of reverting to blast–like cells, and 3.) when so transformed, can multiply as the immunologic need arises.
In normal people, most of lymphocytes are small, innocent–looking round cells with heavily "painted–on" nuclear chromatin, scant watery cytoplasm, and no granules. A small proportion of normal lymphs are larger and have more opaque, "busy–looking" cytoplasm and slightly irregular nuclei. Some of these have a few large, dark blue granules, the so called "azurophilic granules." It has been maintained that these granulated cells are T–gamma cells (i.e., T–cells that have a surface receptor for the IgG Fc region) or natural killer (NK) null–cells. Other phenotypes of lymphocytes are not recognizable as such on the routine, Wright–stained smear and require special techniques for identification.
When activated by whatever means, lymphocytes can become very large (approaching or exceeding the diameter of monocytes) and basophilic (reflecting the increased amount of synthesized cytoplasmic RNA and protein). The cytoplasm becomes finely granular (reflecting increased numbers of organelles), and the nuclear chromatin becomes less clumped (the better to transcribe you with, my dear!). Such cells are called "transformed lymphocytes," "atypical lymphocytes," or "viral lymphocytes" by various votaries of blood smears. Although such cells are classically associated with viral infection (particularly infectious mononucleosis), they may also be seen in bacterial and other infections and in allergic conditions. A morphologic pitfall is mistaking them for monocytes (a harmless mistake) or leukemic blasts (not so harmless).
—Reference—
Vitamin C in excess of our body's cellular needs provides the function of a chelating agent removing harmful materials such as
lead from our bodies. You would need to consume about 20 grams of Vitamin C a day for a couple of weeks to realize any toxic symptoms. ( This follows the general rule that "Twice Optimum is Toxic".
{ Confirmed through my own personal experience —Tommy C— } )
[ Citric Acid is another chelating agent that Nature provides for this purpose. So, keep a good amount of citrus fruits in your diet. Citrus also has bioflavonoids*, which are needed to help Vitamin C properly perform its functions. ]
{ * Bioflavonoids: a derivative of a flavone compound that helps maintain the capillary walls, reducing the likelihood of hemorrhaging. Found in abundance in the white part of an orange rind. }
You need to take "Ascorbic Acid" and Not "Sodium Ascorbate" to realize maximum benefits.
[ 120 mg. of Sodium Ascorbate is equivalent in Vitamin C activity to 100 mg. of Ascorbic Acid.
—The Merck Index— ]
A number of studies have been performed looking at "high levels" of Vitamin C in humans. Some have concluded that high levels are harmful. The authors of these studies have a poor understanding of human biology.
One well-done study noticed that Vitamin C increases the wall thickness of arteries and veins. The author then concluded that this was a bad thing. The story was carried by a national news organization. When other more informed scientists pointed out to them that this was actually good, they refused to air the more informed version of the story.
Our circulatory system's "pipes" need to expand and contract to correct for the changing volume of our blood and body fluids. Studies have discovered that our bodies are about two quarts deficient in water before our
thirst mechanism is activated. If our circulatory system didn't have a way to compensate for this, gravity would
"push" the blood out of our heads resulting in a quick death.
Also, in many people blood vessels are too thin resulting in leaks which cause additional medical problems. In general, we don't have a good understanding of just how thick our circulatory system's walls need to be. We have only recently developed the tools to studying these types of things. Now, somebody has to want to do it and be able to find the funding.
[ The arterial wall is made up largely of two types of cells. The inner cells touching the blood are lining cells. They are flexible, hardy, general-purpose, forgiving, and fill up the space they’re given. These inner cells are the vessel’s basic covering, like living wallpaper. Just under the wallpaper cells is a layer of smooth muscle cells. They are smooth, for they are the conduit of flowing liquids. They are muscle, for they expand to let out heat and contract to stop blood loss at an injury. Smooth muscle cells help the heart balance the flow of blood and oxygen to the parts of the body that need them most.
—Reference— ]
Other studies that have reported supposedly harmful effects, have failed to realize that Vitamin C doesn't work alone in all cases. Bioflavonoids are required for Vitamin C to perform many of its functions and administering Vitamin C at high levels without providing its co–workers can account for the observations they made.
If anyone can find copies of these studies, I would Love to hear from you. —Tommy C—
NATIONAL ACADEMY OF SCIENCES
1975
Throughout history, man has used some 3,000 plants species
for food; (From a possible selection of over 12,000 edible plants.)
at least 150 of them have been commercially cultivated
to some extent. But over the centuries the tendency has been to
concentrate on fewer and fewer. Today, most of the people in the
world are fed by about 20 crops-cereals such as wheat, rice,
maize, and sorghum; root crops such as potato, sweet potato, and
cassava; legumes such as peas, beans, peanuts (ground nuts), and
soybeans; and sugar beet, coconuts, and bananas. These plants
are the main bulwark between mankind and starvation. It is a
very small bastion.
Yet as the prospect of food shortages becomes more acute,
people must depend increasingly on plants rather than animals for
the protein in their diet. As is well recognized, research is
urgently needed to increase the yield of these food plants.
However, reliance on a small number of plants carries great risk,
for monocultures are extremely vulnerable to catastrophic failure
brought about by disease or variations in climate. To help feed
clothe, and house a rapidly increasing world population, it is
timely to consider neglected or little-known plant species.
Man has only just begun to take stock of the chemical and
genetic possibilities in the plant kingdom. Now we must
scrutinize the thousands of plant species, many of which are
still untested and some as yet unidentified.
How does Your Home Garden Rate in Nutrition?
By Lee Svitak Dean
Star Tribune Staff Writer
Wednesday, April 9, 1997
While you're thumbing through seed catalogs, think nutrients as well as
flavor, suggests Sharon Johnson, a student dietitian at the University of
Minnesota. Some vegetables have much more nutritional value than others,
which makes them especially good candidates for the home garden and the
dinner table.
Celery, for example, offers little but fiber and water – which is why it's
often suggested as a diet food. Spinach, on the other hand, offers Vitamins
A, B6, C and K, plus calcium, iron, magnesium, potassium, riboflavin and
folate. If it's a matter of choice, plant spinach rather than celery,
Johnson suggested.
She noted that children over the age of 2 have the same dietary requirements
as adults, which means they should have at least five servings of fruits
and vegetables in their daily diets. "But we need to eat a variety of
fruits and vegetables," she said. "We all need to have more than
140 different nutrients in our diet, to keep our
bodies healthy. If all you eat are apples and corn, you're not going to get
them." Growing dinner vegetables offers an opportunity to get children
interested in produce. "They're likely to taste it when they've grown it,"
she said.
Shari Guski, a horticulturist with the Minnesota State Horticultural Society,
reminds gardeners with limited space, that many vine vegetables (such as
cucumbers and squash), can be grown vertically onto stakes or a trellis to
allow the most use of horizontal space.
She suggests that gardeners read the seed packets carefully for planting directions. She says that gardeners get what they pay for when buying seed. "Cheaper seeds are not as high quality."
The following fruits and vegetables are well suited to the Minnesota backyard garden, and all serve as excellent sources of vitamins and minerals, soluble fiber and carbohydrates. They are naturally low in fat, and contribute a small amount of protein in the diet.
The list from Johnson that follows indicates what each type of produce provides as a good source:
- Asparagus: Vitamins A, C and E, folate and potassium.
- Beans, snap: Vitamin K.
- Beets, greens: Calcium, folate and magnesium.
- Black-eyed peas: Magnesium and zinc.
- Broccoli: Vitamins A, B6, C and K calcium, folate, magnesium, pantothenic acid and riboflavin.
- Brussels sprouts: Vitamin C.
- Cabbage: Vitamin K.
- Cantaloupe: Vitamins A, B6 and C, folate and potassium.
- Carrots: Vitamin A.
- Cauliflower: Vitamin C and biotin.
- Eggplant: Folate and potassium.
- Green peas: Vitamins C and K, and iron.
- Kale: Vitamin K.
- Kohlrabi: Vitamin C and potassium.
- Mesclun (salad greens): Vitamin A and C, and folate.
- Mustard greens: Vitamins A and C.
- Parsnips: Vitamin C, calcium, magnesium and potassium.
- Pepper: green: Vitamin C.
- Potatoes: Vitamin C and potassium.
- Rhubarb: Calcium and potassium.
- Rutabagas: Vitamin C, magnesium and potassium.
- Spinach: Vitamins A, B6, C and K, calcium, iron, magnesium, potassium,
riboflavin and folate.
- Squash, winter or zucchini: Vitamin A and potassium.
- Sweet corn: Magnesium and potassium.
- Sweet potatoes: Vitamins A and C.
- Tomatoes: Vitamins A and C.
- Turnip greens: Vitamins A and K, calcium and folate.
- Watermelon: Vitamin B6 and thiamin.
A BUSHEL A DAY
— by Tommy Cichanowski.
A bushel a day He gives me,
A bushel a day to share.
So much love to give away,
To show how much I care.
Each day He fills me up,
And sends me out to play.
With all the things, He made for us,
And to help others, on their way.
© Tommy Cichanowski
Aging occurs when our body's cells lose their ability
to fully replicate and regenerate themselves.
THE ORIGIN AND USE OF OUR BODY'S ENERGY
— Special Plants —
Jewel Weed — a Magical Poison-ivy Antidote
If the stem is crushed, and the juice rubbed into the skin contacted by the poison ivy, symptoms will not appear or will be much less troublesome.
Plantain —
for Bee stings, many Insect bites, Red Ant bites
Link to www.botanical.com
It should be chewed or crushed well and rubbed into affected area for several minutes.
Just a Picture of Plantain
Link to more Tortoise Shell information ...
Plantain is an eatable plant.
Carbon Monoxide Poisoning
(Russian Research)
Large quantities of Vitamin C will remove Carbon Monoxide from Hemoglobin.
20 grams per day
(And even more, if you are under a doctor's care)
can be safely taken for several days.
Here is the Science for Understanding Why This Works.
Carbon Monoxide is a Cation, and Vitamin C operates as an Anionic Surfactant.
How Vitamins Were Discovered
Your Body's Own Natural Defenses can Strengthen to "Rid You of Cancer" !
Appendixes from "The Persecution and Trial of Gaston Naessens" by Christopher Bird
The True Story of the Efforts to Suppress an Alternative Treatment for Cancer,
AIDS, and Other Immunologically Based Diseases.
Why Animals Don't Get Heart Attacks ... But People Do!
Matthias Rath, MD discusses his studies with Vitamin C and other Nutrients
Animals have an Enzyme in their Livers that makes Vitamin C !!! Lots of it !!!
Vitamin C controls “Free Radicals” a major factor in Curing Cancer.
Keeping Ourselves Alive
Nutrition Research Resources
The Physical Water of Life —
Make Your Own "Water ..."
Web Site Link List —
A Sample Hydroculture Solution
The Tortoise Shell "Science of Health" Newsletter
— Putting an End to Disease on Our Planet —
The Tortoise Shell Life Science Puzzle
Box – Front Page
View this page Full Frame
|

 Water's unique geometry does give it some very interesting properties. Water's two hydrogen atoms are not across from each other as one might expect from the "Ideal of Symmetry" or charge distribution.
Some atoms have electrons in orbits that very closely resemble those of comets, as well as Earth type orbits. Atoms also have a strong preference as to the sequence in which the different possible orbital regions are populated with electrons.
Water's unique geometry does give it some very interesting properties. Water's two hydrogen atoms are not across from each other as one might expect from the "Ideal of Symmetry" or charge distribution.
Some atoms have electrons in orbits that very closely resemble those of comets, as well as Earth type orbits. Atoms also have a strong preference as to the sequence in which the different possible orbital regions are populated with electrons.
 Water's Hydrogen atoms are grouped to one side. This allows a small
Water's Hydrogen atoms are grouped to one side. This allows a small


 The presence of the four hydroxyl groups ( OH– ) makes this molecule a very good
The presence of the four hydroxyl groups ( OH– ) makes this molecule a very good